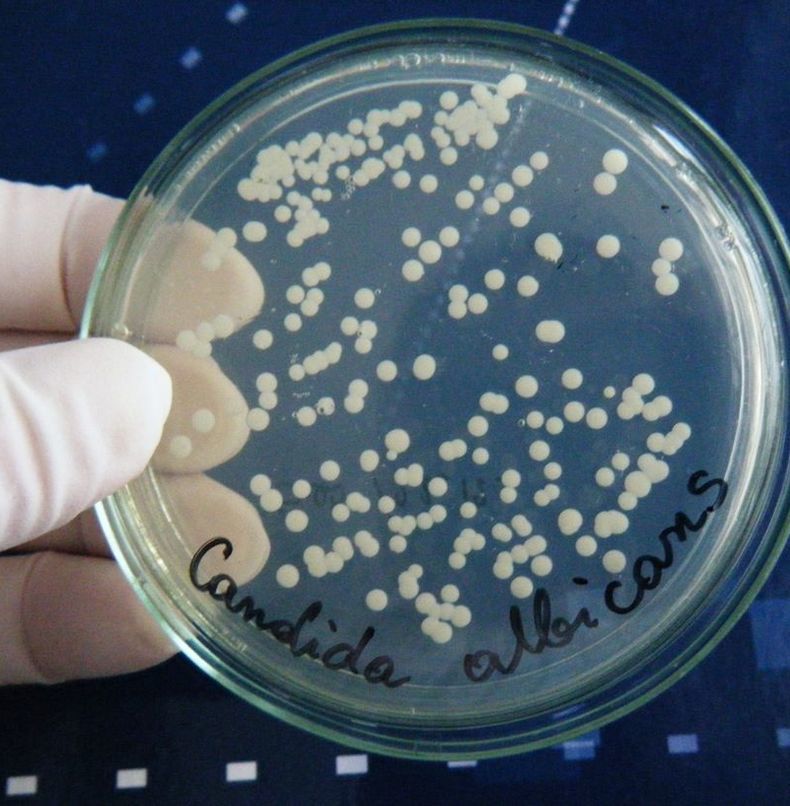

Грибковая инфекция, или по-научному кандидоз — распространённое заболевание, которую вызывает грибок рода Candida.
Практически все врачи включают в комплексную терапию, наряду с лекарственными препаратами, лечебное питание. Лечение и диета обязательно должны идти параллельно.
Мы расскажем вам о 10 продуктах, которые естественным образом борются с кандидой.
Лечение кандидоза
1. Яблочный уксус
Органический яблочный уксус — эффективное лекарственное средство для лечения молочницы. Он содержит естественные ферменты, которые помогают замедлить рост грибка Candida и изменяет для его развития среду. Уксус можно использовать при лечении молочницы во рту, на коже, в кишечнике и при вагинальной инфекции. Необходимо тщательно выбирать яблочный уксус перед покупкой. Для лучших результатов лучше выбирать нефильтрованный и не пастеризованный.
Для лечения молочницы во рту нужно развести 2 ч. л. уксуса с 8 ч. л. воды и прополоскать в течении пары минут. Процедуру проводят три раза в день до исчезновения симптомов. При молочнице на коже применяют ванны: два стакана уксуса на ванну с теплой водой. Вода должна покрывать все пораженные участки. Принимать ванну по полчаса, один раз в день, до снятия симптомов.
При лечении молочницы в кишечнике приготовить напиток. 2 ст. л. уксуса на 8 ст. л. воды, выпивать два раза в день. При лечении вагинальной молочницы принимают ванну, описанную выше или спринцевания. Уксус разбавляют 1:1 и спринцуются кружкой Эсмарха два раза в день.
2. Квашенная капуста
Одним из самых простых и распространённых продуктов при кандидозе, является квашенная капуста. Капуста содержит пробиотики, которые необходимы не только для правильного переваривания пищи, но и для укрепления иммунной системы. Квашенная капуста заселяет кишечник полезными микроорганизмами, которые борются с паразитами, грибками и дрожжами.
3. Не крахмалистые овощи
Во время диеты следует исключить крахмалистые овощи, наиболее предпочтительными будут помидоры, огурцы, брюква, лук. Их можно есть как в сыром, так и в запеченном виде. Зеленые листовые овощи богаты фолиевой кислотой, которая очень часто рекомендуется врачами при лечении молочницы.
4. Кокосовое масло
Органическое кокосовое масло содержит вещества с противогрибковыми свойствами, известное как киприловая и лауриновая кислота. Эти кислоты препятствуют росту кандиды, закрывая отверстия в стенках дрожжевых клеток и заставляя их отмирать. Кокосовое масло также способствует очищению организма от токсинов, накапливающихся в результате распада дрожжей.
Применять кокосовое масло можно внутрь и наружно. На нем можно готовить или просто принимать по 1 ч. л., постепенно доходя до 3 ст. л. Для внутривагинального лечения используют тампон, промоченный теплым маслом.
Продукты при кандидозе
Чеснок входит в рейтинг 10 продуктов, заменяющих антибиотики. Он содержит аллицин — серосодержащие соединение с естественными противогрибковыми свойствами. Этот продукт может за короткое время уничтожить всю колонию грибка — на самом деле кандидоз не сможет выжить, если присутствует чеснок.
Если вы любите чеснок, то для вас не будет проблемой как его употреблять. Достаточно 2 зубчиков в сутки для борьбы с заболеванием. Если вы не любитель чеснока, то его можно принимать в капсулах, чеснок начнет растворятся в кишечнике, что заодно предотвратит запах. При лечении вагинальной молочницы применяют ватно-марлевые тампоны, смоченные в настое чеснока и спринцевания с настоем чеснока.
6. Масло и семена льна
Очень эффективны при лечении молочницы льняное масло и семена льна. Их обязательно нужно включить в свой рацион. Пол столовой ложки льняного масла дважды в день будет достаточно. Для семян нужно делать настой. На соловую ложку семян залить в термос 300 мл кипятка. На следующий день настой готов. Выпивайте настой в течении дня. Курс лечения до полного исчезновения симптомов.
7. Кисломолочные продукты
При молочнице можно и нужно употреблять кисломолочные продукты, в составе которых содержатся бифидо и лактобактерии. Кефир, простокваша, несладкий йогурт, сметана, творог — при молочнице дадут положительный эффект. Кисломолочные продукты тормозят процесс активности патогенной флоры, тем самым оказывая оздоровительный эффект. Во время лечения можно употреблять и молоко, если только оно прошло ферментативную обработку.
В качестве активного средства борьбы с кандидозом очень хорошо подходят специи, такие как корица, лавровый лист, гвоздика. Корица повреждает клетки дрожжей, лишает их естественных свойств и в конце концов заставляет их погибать. Использование гвоздичного масла в качестве противогрибковых препаратов неоднократно подтверждено исследованиями. Фитонциды, содержащиеся в лавровом листе, помогают вывести токсины и шлаки из организма и способствуют быстрому избавлению от молочницы.
9. Костный бульон
Бульон издавна используется в народной медицине. Он прекрасно восстанавливает микрофлору кишечника и функции пищеварительного тракта. Костный бульон содержит минералы в легкоусвояемой форме и аминокислоту глицин, которая стимулирует синтез соляной кислоты в желудке. Также, в бульоне содержится не менее важная аминокислота глутамин и коллаген. Все это улучшает рост и развитие микрофлоры кишечника, создавая благоприятную обстановку для полезных бактерий.
10. Оливковое масло
Оливковое масло содержит олеиновую кислоту, которая вызывает сильные противогрибковые эффекты и стимулирует иммунные реакции организма человека на бактерии молочницы. Также масло является источником жирных кислот Омега-3 и полифенолов, двух компонентов, которые укрепляют защитные силы организма и борются с грибком Candida.
Решающим фактором при лечении кандидоза является бездрожжевое питание и включение в рацион белковой нежирной пищи, а также продуктов богатыми пробиотиками.
Продукты, которые следует избегать
В первую очередь это сахар, копчёности, жирные и маринованные продукты. А также алкоголь, который способствует повышению кислотности в кишечнике и желудке. Следует исключить употребление простых углеводов, потому что это питательная среда для кандид.
Практически метод диетического лечения сводится к основной задаче — нормализации кислотной и щелочной среды, которая является губительной для многих вредоносных микроорганизмов, в том числе и для грибов Candida. Диета при лечении молочницы должна соблюдаться в течении трех месяцев и после исчезновения симптомов. Будьте здоровы.
Тесты на кандидоз
Какие продукты эффективно борются с молочницей? Практически метод диетического лечения сводится к основной задаче — нормализации кислотной и щелочной среды, которая является губительной для многих вредоносных микроорганизмов, в том числе и для грибов Candida.

Грибковая инфекция, или по-научному кандидоз — распространённое заболевание, которую вызывает грибок рода Candida. Практически все врачи включают в комплексную терапию, наряду с лекарственными препаратами, лечебное питание. Лечение и диета обязательно должны идти параллельно. Мы расскажем вам о 10 продуктах, которые естественным образом борются с кандидой.
10 продуктов для борьбы с кандидозом
- Лечение кандидоза
- Продукты при кандидозе
- Тесты на кандидоз — Видео
Органический яблочный уксус — эффективное лекарственное средство для лечения молочницы.
Он содержит естественные ферменты, которые помогают замедлить рост грибка Candida и изменяет для его развития среду. Уксус можно использовать при лечении молочницы во рту, на коже, в кишечнике и при вагинальной инфекции. Необходимо тщательно выбирать яблочный уксус перед покупкой. Для лучших результатов лучше выбирать нефильтрованный и не пастеризованный.

Для лечения молочницы во рту нужно развести 2 ч. л. уксуса с 8 ч. л. воды и прополоскать в течении пары минут. Процедуру проводят три раза в день до исчезновения симптомов. При молочнице на коже применяют ванны: два стакана уксуса на ванну с теплой водой. Вода должна покрывать все пораженные участки. Принимать ванну по полчаса, один раз в день, до снятия симптомов.
При лечении молочницы в кишечнике приготовить напиток. 2 ст. л. уксуса на 8 ст. л. воды, выпивать два раза в день. При лечении вагинальной молочницы принимают ванну, описанную выше или спринцевания. Уксус разбавляют 1:1 и спринцуются кружкой Эсмарха два раза в день.
Одним из самых простых и распространённых продуктов при кандидозе, является квашенная капуста. Капуста содержит пробиотики, которые необходимы не только для правильного переваривания пищи, но и для укрепления иммунной системы. Квашенная капуста заселяет кишечник полезными микроорганизмами, которые борются с паразитами, грибками и дрожжами.
Во время диеты следует исключить крахмалистые овощи, наиболее предпочтительными будут помидоры, огурцы, брюква, лук. Их можно есть как в сыром, так и в запеченном виде. Зеленые листовые овощи богаты фолиевой кислотой, которая очень часто рекомендуется врачами при лечении молочницы.

Органическое кокосовое масло содержит вещества с противогрибковыми свойствами, известное как киприловая и лауриновая кислота. Эти кислоты препятствуют росту кандиды, закрывая отверстия в стенках дрожжевых клеток и заставляя их отмирать. Кокосовое масло также способствует очищению организма от токсинов, накапливающихся в результате распада дрожжей.
Применять кокосовое масло можно внутрь и наружно. На нем можно готовить или просто принимать по 1 ч. л., постепенно доходя до 3 ст. л. Для внутривагинального лечения используют тампон, промоченный теплым маслом.
Чеснок входит в рейтинг 10 продуктов, заменяющих антибиотики. Он содержит аллицин — серосодержащие соединение с естественными противогрибковыми свойствами. Этот продукт может за короткое время уничтожить всю колонию грибка — на самом деле кандидоз не сможет выжить, если присутствует чеснок.
Если вы любите чеснок, то для вас не будет проблемой как его употреблять. Достаточно 2 зубчиков в сутки для борьбы с заболеванием. Если вы не любитель чеснока, то его можно принимать в капсулах, чеснок начнет растворятся в кишечнике, что заодно предотвратит запах. При лечении вагинальной молочницы применяют ватно-марлевые тампоны, смоченные в настое чеснока и спринцевания с настоем чеснока.
Очень эффективны при лечении молочницы льняное масло и семена льна. Их обязательно нужно включить в свой рацион. Пол столовой ложки льняного масла дважды в день будет достаточно. Для семян нужно делать настой. На соловую ложку семян залить в термос 300 мл кипятка. На следующий день настой готов. Выпивайте настой в течении дня. Курс лечения до полного исчезновения симптомов.

При молочнице можно и нужно употреблять кисломолочные продукты, в составе которых содержатся бифидо и лактобактерии. Кефир, простокваша, несладкий йогурт, сметана, творог — при молочнице дадут положительный эффект. Кисломолочные продукты тормозят процесс активности патогенной флоры, тем самым оказывая оздоровительный эффект. Во время лечения можно употреблять и молоко, если только оно прошло ферментативную обработку.
В качестве активного средства борьбы с кандидозом очень хорошо подходят специи, такие как корица, лавровый лист, гвоздика. Корица повреждает клетки дрожжей, лишает их естественных свойств и в конце концов заставляет их погибать. Использование гвоздичного масла в качестве противогрибковых препаратов неоднократно подтверждено исследованиями. Фитонциды, содержащиеся в лавровом листе, помогают вывести токсины и шлаки из организма и способствуют быстрому избавлению от молочницы.
Бульон издавна используется в народной медицине. Он прекрасно восстанавливает микрофлору кишечника и функции пищеварительного тракта. Костный бульон содержит минералы в легкоусвояемой форме и аминокислоту глицин, которая стимулирует синтез соляной кислоты в желудке. Также, в бульоне содержится не менее важная аминокислота глутамин и коллаген. Все это улучшает рост и развитие микрофлоры кишечника, создавая благоприятную обстановку для полезных бактерий.

10. Оливковое масло
Оливковое масло содержит олеиновую кислоту, которая вызывает сильные противогрибковые эффекты и стимулирует иммунные реакции организма человека на бактерии молочницы. Также масло является источником жирных кислот Омега-3 и полифенолов, двух компонентов, которые укрепляют защитные силы организма и борются с грибком Candida.
Решающим фактором при лечении кандидоза является бездрожжевое питание и включение в рацион белковой нежирной пищи, а также продуктов богатыми пробиотиками.
В первую очередь это сахар, копчёности, жирные и маринованные продукты. А также алкоголь, который способствует повышению кислотности в кишечнике и желудке. Следует исключить употребление простых углеводов, потому что это питательная среда для кандид.
Практически метод диетического лечения сводится к основной задаче — нормализации кислотной и щелочной среды, которая является губительной для многих вредоносных микроорганизмов, в том числе и для грибов Candida. Диета при лечении молочницы должна соблюдаться в течении трех месяцев и после исчезновения симптомов. Будьте здоровы.опубликовано econet.ru.
Хронические болезни: Других нет
На сервисе СпросиВрача доступна консультация гинеколога по любой волнующей Вас проблеме. Врачи-эксперты оказывают консультации круглосуточно и бесплатно. Задайте свой вопрос и получите ответ сразу же!

Вызывает кандидоз дрожжеподобный грибок Кандида. В норме он присутствует в микрофлоре слизистых в определенном количестве. При благоприятных факторах грибки начинают активно размножаться, вызывая кандидоз. Перед тем как подбирать средство от грибка, нужно установить точный диагноз, поскольку есть другие болезни со схожей картиной.
Причины кандидоза кишечника
Невылеченные вовремя заболевания кишечника могут негативно повлиять на работу других органов и систем, важно прислушиваться к сигналам организма и беречь здоровье.
Причинами, по которым прямая или толстая кишка поражается грибками, становятся:
- Несбалансированный рацион питания. Безобидный фактор, при коррекции которого удается быстро избавиться от болезни.
- Плохая экологическая обстановка. Проживание в промышленных зонах стало фактором, вызывающим заболевания, включая молочницу.
- Курение, злоупотребление алкоголем. Вредные привычки потому названы так, потому что не несут пользы организму. Алкоголь уничтожает полезные бактерии в микрофлоре кишечника, если употреблять его часто.
- Длительный прием антибиотиков и гормональных лекарств.
- Сахарный диабет, ВИЧ, онкология.
- Несоблюдение элементарных правил гигиены.
- Пожилой возраст.
- Период беременности.
Симптомы и диагностика кандидоза в кишечнике
Одним из основных способов выявить кандидоз кишечника является взятие мазка со слизистой для микроскопического исследования. Дополнительно сдается кал на анализ. В лаборатории проводят культуральную диагностику, полимеразную цепную реакцию, иммуноферментный анализ.
Существует способ диагностировать кандидоз дома – утром, еще до чистки зубов, нужно плюнуть в стакан с кипяченой водой. Сначала слюна будет оставаться на поверхности воды. Если спустя полчаса она опустится на дно, это может быть сигналом чрезмерной активности грибка в организме. Если слюна осталась на поверхности – вероятность кандидоза мала, а причину проблем с кишечником следует искать потом.
При кандидозе кишечника пациент испытывает традиционный набор симптомов:
- повышенное газообразование на фоне другой симптоматики;
- понос, сопровождающийся слизью и белыми вкраплениями;
- дискомфорт и спазмы в области желудка после еды, вздутие;
- наличие творожистых вкраплений в кале — основной симптом болезни, но для окончательной диагностики требуется медицинское обследование. Иногда достаточно коррекции рациона и отказа от алкоголя для нормализации микрофлоры.
Народные средства от кандидоза кишечника

Утром нужно выпивать натощак стакан теплого отвара, чтобы вскоре убедиться, что микрофлора приходит в норму. Чтобы приготовить отвар понадобится заварить 30 г сушеной травы стаканом кипятка.
Можно готовить не только чистые отвары, но смешивать лекарственные травы.
Отвар из овса действует на кишечник. Для приготовления отвара на весь курс лечения понадобится 10 стаканов овса и 30 стаканов воды. Можно готовить лечебный отвар порционно, подобрав дозировку. Смешивают воду с овсом в посуде, затем ставят на огонь и варят 3 часа. Готовый отвар процеживается, хранится в холодильнике. Принимать овсяный отвар нужно трижды в день по полстакана. Курс – от 2 до 4 месяцев.
Бальзам от кандидоза – проверенное народное средство. Нужно взять по 2 лимона и апельсина, выжать сок и поместить в стеклянную емкость. Туда добавить 4 натертых луковицы, 10 ст. л. натурального меда. Смесь перемешивается, хранится в холодильнике. Принимать нужно по 1 ст.л. 4 раза в день.
Сода считается средством, которым можно лечить грибок любой локализации. Несмотря на безопасность соды, нужно соблюдать дозировку, в больших количествах можно нанести вред организму. При кандидозе кишечника грибковый налет образуется не только на стенках кишки, но и во рту. Для полоскания ротовой полости используют содовый раствор – растворяют 0,5 ч.л. соды в стакане воды. Этим раствором можно протирать кожу вокруг анального отверстия, чтобы снять зуд и жжение. Если на фоне болезни наблюдаются запоры, можно делать клизмы с содой. В этом случае в 1 л. кипяченой воды добавляют 1 ч.л. соды. Процедура подходит взрослым и детям.
Чай из укропа назначают женщинам и мужчинам, его можно давать детям, хотя для них в аптеке можно купить укропную воду. Для приготовления лечебного чая 1 ч.л. укропа заваривают стаканом кипятка. Чай остужают, процеживают и пьют дважды в день.
Лимонный сок поможет подкислить организм, чтобы избавить от избытка грибка. Употреблять сок лимона рекомендуют по трети стакана утром до еды. С осторожностью нужно принимать людям с заболеваниями желудка. Лучше посоветоваться с врачом. Взрослые пьют чистый сок лимона, детям его разбавляют кипяченой водой.
Масло душицы укрепляет защитные силы организма, что позволяет справляться с грибком. Для применения масло нужно развести кипяченой водой. Другой вариант – пить томатный сок, в который добавлено несколько капель масла душицы. Пьют его либо натощак утром, либо перед сном.
Алоэ – растение, помогающее при разных болезнях. Свежий сок растения помогает при кандидозе кишечника. На вкус он достаточно горький, поэтому его можно смешивать с таким же количеством натурального меда. Полученную смесь принимают по 1 ст.л. за час до еды. Если возле анального отверстия ощущается зуд, его можно снять соком алоэ. Для этого свежие листья перерабатывают в кашицу, перетирают через марлю или сито, полученным соком мажут пораженные очаги.
Хорошо зарекомендовал себя в лечении грибка чеснок. Чтобы получить результат, нужно ежедневно употреблять порцию морковного салата с чесноком или просто съедать пару зубчиков чеснока.
Желательно провести полноценный курс терапии чесноком. Начинают его с 2 зубчиков в день, постепенно увеличивая его количество в ежедневном рационе до 10-12 шт.
При этом за час до чеснока и спустя час после его приема не следует что-либо пить. Другой вариант лечения – употребления настоя молочного гриба в сочетании с чесноком. Для приготовления лечебного средства понадобится 1 стакан настоя молочного гриба и 3 измельченных зубчика чеснока. Полученную смесь нужно медленно выпить непосредственно перед сном, задерживая каждый глоток ненадолго во рту.
Еще популярным народным средством от грибка является овсяный кисель. Для его приготовления нужно заполнить 3-литровую стеклянную банку овсяными хлопьями, залить смесью кефира с водой.
Вместо крышки банку прикрывают марлей, сложенной в несколько раз. Емкость убирают в тепло на 3 дня, чтобы содержимое забродило. Спустя положенное время из банки сливают жидкость, а осадок хранят в холодильнике для дальнейшего применения. Ежедневно нужно брать по 2-3 ст. л. осадка из банки, заливать 0,5 л воды и доводить до кипения. После того, как лечебный кисель остынет, можно его пить. Он прекрасно сочетается с фруктами, овощами и зеленью.
Питание при кандидозе кишечника

При выборе продуктов, следует помнить, что некоторые из них создают благоприятные условия для размножения патогенных микроорганизмов, а другие способствуют гибели грибков, вредных бактерий.
При лечении кандидоза в кишечнике рекомендуется снизить потребление продуктов, содержащих в составе простые углеводы. Это дрожжевая выпечка, всевозможные десерты, фруктовые соки из магазина, мед и сахарная свекла, фруктоза, сахар в любом виде, алкоголь. Нужно уменьшить количество чая и кофе, выпитого за день. Эти напитки могут снижать эффективность антимикозных препаратов.
Что касается полезных для кишечника продуктов во время лечения ⏤ кисломолочная продукция, насыщенная бифидобактериями. Если в магазине нет продуктов, можно ввести в рацион кефир, йогурт из козьего молока.
Закваску для приготовления домашних кисломолочных продуктов можно купить в аптеке. Полезный кефир, творог и ряженка нормализуют микрофлору в кишечнике, создают неблагоприятную среду для грибков.
Включить в рацион нужно нежирное мясо и рыбу, овощи и зелень, кислые фрукты, яйца и орехи. Мясо употреблять в вареном (тушеном) виде, а рыбу рекомендуется готовить на пару.
Ежедневно ввести в рацион 2 ст. л. оливкового, рапсового или льняного масла. Они содержат в своем жирные ненасыщенные кислоты, которые несут огромную пользу организму. Масла укрепляют иммунную систему, обладают противовоспалительными свойствами.
Обязательно нужно пить много воды, грибки во время своей жизнедеятельности выделяют много токсинов. Чтобы их вывести из организма, нужно много чистой воды, выпивать воду маленькими глотками и медленно.

Тест на молочницу: как проводится? В чем особенности?

Молочница перед месячными, что делать и как лечить?
Сода от молочницы можно использоваться как дополнительный способ терапии вместе с лекарственными препаратами. Это поможет организму быстрее справиться с грибковой инфекцией. Молочница (кандидоз) — неприятное заболевание, сопровождающееся воспалением и сильным зудом. Подмывания и спринцевания раствором соды быстро избавляют от дискомфорта и способствуют излечению. Лечение кандидоза содой признано как врачами, так и народной медициной.
Что такое молочница?
Молочница — это заболевание, вызванное дрожжевым грибком кандида. Иначе эту болезнь называют кандидозом. Грибковая инфекция у женщин чаще всего поражает половые органы.
Это очень распространенная инфекция, ведь кандида в норме содержится во влагалище у большинства женщин. Не всегда наличие грибка приводит к болезни. Только при неблагоприятных условиях, особенно при сниженном иммунитете, грибок начинает усиленно размножаться и вызывает молочницу. По наблюдениям медиков больше половины женщин хотя бы раз в жизни переболели кандидозом.
Грибок вызывает воспаление влагалища — кандидозный вагинит. Это заболевание проявляется сильным зудом, белыми творожистыми выделениями с кисловатым запахом, болезненностью при мочеиспускании.
Чаще молочницей болеют женщины. Однако кандидоз встречается и у мужчин, в этом случае грибковая инфекция поражает крайнюю плоть и головку полового члена. Возникает заболевание — кандидозный баланопостит. У мужчин молочница протекает тяжелее: поднимается температура тела, ухудшается общее самочувствие. Головка и крайняя плоть краснеют и отекают, ощущается сильное жжение и зуд.
Кандидозом может заболеть и ребенок. В детском возрасте грибок чаще всего поражает ротовую полость. Слизистая оболочка рта воспаляется, на деснах и языке появляется белый налет. Ребенка беспокоит зуд во рту.
Молочница — это болезнь, требующая безотлагательного лечения. Запущенный кандидоз может стать хроническим. Кроме того, грибковая инфекция может распространяться по организму и вызывать осложнения. У женщин и мужчин молочница может переходить восходящим путем на другие органы: мочеиспускательный канал, мочевой пузырь и почки. А у детей грибковая инфекция из ротовой полости может распространяться на глотку и верхние дыхательные пути.
Принцип действия соды при молочнице
Пациентов интересует вопрос: можно ли лечить молочницу содой и как действует это средство? Прежде всего нужно разобраться в химическом составе этого вещества. Сода представляет собой щелочь. Когда кислая среда вступает во взаимодействие с щелочным раствором, происходит реакция нейтрализации. При размножении грибок выделяет кислоту. Сода при молочнице помогает нейтрализовать кислотные продукты жизнедеятельности кандиды.
При заболевании грибок проникает глубоко под кожу. А раствор соды впитывается во внутренние кожные слои, создавая там щелочную среду. В таких условиях кандиды не могут выжить и вскоре погибают. Таким образом сода действует как местное дезинфицирующее средство.
Лечение молочницы в домашних условиях с использованием соды имеет много преимуществ:
- Слизистая оболочка под действием щелочного раствора становится более сухой, а это препятствует размножению инфекции.
- Такой способ лечения достаточно безопасен.
- Сода не влияет на естественную микрофлору организма.
- В раствор соды при молочнице можно добавлять дополнительные компоненты: отвары трав, йод, поваренную соль. Это усиливает противовоспалительный эффект.
Как лечить молочницу содой? Использование этого вещества при кандидозе может быть многообразным. Раствор соды можно применять для подмывания, спринцевания, полоскания (при кандидозе ротовой полости), а также для приема внутрь.
Перед лечением этим домашним средством необходима медицинская консультация. Ведь при относительной безопасности этого метода его можно применять не всем пациентам. Только лечащий врач может выявить наличие всех показаний и противопоказаний.
- Лечение молочницы содой при беременности имеет некоторые особенности. Нельзя спринцеваться содой на ранних сроках и в третьем триместре, так как это может спровоцировать выкидыш или внутриутробное заражение плода. Содовый раствор можно использовать только для подмывания.
- Не следует использовать содовый раствор в течение первого месяца после искусственного прерывания беременности.
- Этот метод не рекомендуется при эрозии влагалища. А также спринцевания и подмывания раствором соды противопоказаны при воспалении и эрозии шейки матки.
- Нельзя подмываться и спринцеваться содовым раствором перед посещением врача и сдачей анализов на грибок. Это может исказить клиническую картину заболевания и результаты исследования.
Пищевая сода от молочницы может вызывать и побочные действия. Щелочь может слишком сильно пересушить слизистую оболочку. В этом случае возникает покраснение, усиливается зуд, ощущается жжение. Поэтому не следует слишком часто подмываться содой при молочнице. Этот метод можно применять лишь как дополнение к комплексной терапии или как средство для профилактики кандидоза.
Как приготовить содовый раствор от кандидоза половых органов?
Подмывание содой при молочнице помогает только в первые дни заболевания. Использование содового раствора следует применять вместе с противогрибковыми лекарствами. Это способствует быстрому исчезновению неприятных симптомов.
- В 1 л воды растворяют 1 ч. л. соды. Этим раствором необходимо регулярно подмываться.
- Процедуру нужно продолжать и после исчезновения зуда. Кандида может оставаться в глубоких слоях кожи даже тогда, когда все признаки молочницы утихли.
В раствор соды от молочницы можно добавить йод. Это поможет избежать воспаления. К кандидозу часто присоединяются другие инфекции половых органов. Этот состав поможет предупредить развитие бактерий, так как йод обладает сильными дезинфицирующими свойствами.
- В 1 л кипяченой воды растворяют 1 ст. л. соды и 1 ч. л. йода. Полученный раствор помещают в ванночку.
- В течение недели проводят подмывание этим средством по 15-20 минут в день.
Можно добавлять в содовый раствор для подмывания отвары трав: ромашки, коры дуба, зверобоя. Это способствует усилению противовоспалительного эффекта.
- В 1 л отвара трав добавляют 1 ст. л. соды. Жидкость выливают в ванночку.
- Далее необходимо присесть на ванночку так, чтобы жидкость омывала половые органы.
- Процедуру повторяют по полчаса каждый день.
Хорошим средством для избавления от кандидоза является раствор соды, соли и йода.
- 30 г соли нужно добавить в 1 л воды и прокипятить 3 минуты. Затем жидкость охладить и добавить по 5 г соды и йода.
- Полученным средством необходимо спринцеваться 2 раза в день.
Перед проведением спринцевания нужно обязательно посоветоваться с лечащим врачом. Важно правильно выполнить каждый этап проведения процедуры.
- Перед тем как приступить к спринцеванию, необходимо вымыть руки.
- Нужно наполнить спринцовку лечебным раствором.
- Заранее нужно подготовить ванночку. Затем необходимо сесть над ванночкой и ввести во влагалище кончик спринцовки.
- Медленно и осторожно нужно выдавить раствор внутрь влагалища. Жидкость должна омыть стенки вагины, не задерживаться внутри и свободно вытекать.
- После окончания процедуры не следует подмываться. Лечебный раствор должен впитаться.
- Нельзя проводить спринцевание в первые месяцы беременности и вскоре после родов.
- Процедуру не проводят при воспалении внутренних половых органов.
- Не стоит спринцеваться перед визитом к врачу-гинекологу.
Можно ли подмываться содой мужчинам при кандидозе? Безусловно, такая процедура поможет быстрее вылечить молочницу. Но подмывание может дать результаты только в первые дни болезни. Если при первых признаках заболевания в течение 2 недель проводить омывание полового члена раствором соды, то это избавит от неприятных проявлений.
Против молочницы можно использовать компрессы с раствором соды и отварами трав. У мужчин грибковая инфекция часто распространяется на область ануса. Сода при кандидозе анальной области может применяться в виде клизм. Можно промыть область прямой кишки ватой, смоченной в лечебном растворе.
Для лечения кандидоза у мужчин используют следующий состав с содой:
- Надо вскипятить воду и в 1 л кипятка растворить 1 ст. л. пищевой соды. При сильно выраженных симптомах болезни необходимы пропорции — 1 ч. л. вещества на 500 мл воды. Перед применением жидкость охлаждают до комнатной температуры.
- Соду нужно растворить полностью, так как частички вещества могут повредить слизистую оболочку головки полового члена.
- Во время приготовления состава нельзя использовать прохладную воду. Соду можно растворять только в горячей воде.
Можно сделать ванночку с пищевой содой.
- 1 ст. л. соды растворяют в 1 л горячей кипяченой воды. Для усиления дезинфицирующего эффекта в жидкость добавляют 10 капель йода.
- Жидкость охлаждают и наливают в емкость.
- Нужно присесть над ванночкой и на полчаса поместить половые органы в жидкость. Если в состав добавлен йод, то процедуру проводят 10 минут.
- Если есть противопоказания к применению йода, то его можно заменить настоем календулы или ромашки.
- Лечение содой полезно сочетать с медикаментозными местными средствами. После процедуры можно нанести на больное место противогрибковую мазь.
Содовый раствор при молочнице можно использовать не только как местное средство. Питье раствора тоже может принести пользу. Однако сода от молочницы при беременности не должна применяться как внутреннее средство. Беременным показаны только подмывания лечебным составом.
Прием соды внутрь восстанавливает кислотно-щелочной баланс. Организм мобилизует свои силы и начинает быстрее избавляться от грибковой инфекции. Однако этим средством не стоит злоупотреблять, так как оно может вызвать вздутие живота и метеоризм.
- Лечение начинают с 1/5 ч. л. соды на 1 стакан воды. Постепенно количество вещества доводят до 1/2 ч. л.
- Соду растворяют в теплой воде и принимают 2 раза в день.
- Пить состав надо на голодный желудок за полчаса до еды. Не рекомендуется пить раствор после употребления пищи.
И у взрослых людей, и у детей грибок может поражать не только половые органы, но и полость рта. Далее инфекция может распространиться на глотку. В этом случае лечение молочницы должно проходить на фоне приема пробиотиков. Эти лекарства помогут организму восстановить нормальную микрофлору полости рта, что способствует быстрому избавлению от грибка.
Для полоскания рта нужно приготовить раствор: на 1 стакан воды надо взять 1 ст. л. соды и 2 капли йода. Этим составом надо полоскать рот 3 раза в день. Это средство подходит только для взрослых. Если мы лечим домашними средствами детей, то применять полоскание не стоит.
У детей грибок кандида обычно поражает ротовую полость. Детский кандидоз может наблюдаться даже у грудничков. Лечение молочницы у детей проводится только методом протирания полости рта. Для этого можно использовать следующий рецепт:
- В 250 мл горячей воды растворяют 1 ч. л. соды.
- В этом составе необходимо смочить кусочек марли и протереть рот ребенку, убирая белый налет. Марлю надо периодически менять во время процедуры.
- Рот протирают содовым раствором 6 раз в день после кормления.
- Если ребенок начинает нервничать и не открывает рот во время процедуры, можно смочить в растворе соску.
Можно сделать вывод, что лечение молочницы с применением содового раствора может быть эффективным, если его применять в комплексе с медикаментозным лечением. Благодаря щелочной реакции и дезинфицирующим свойствам соды можно быстро избавиться от симптомов молочницы и не допустить перехода болезни в хроническую стадию.
Читайте также:









